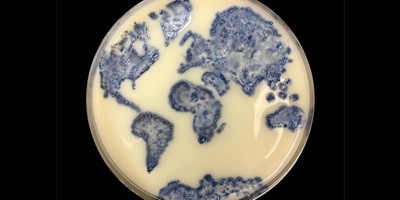
Вчені відстежили поширення стійкості до антибіотика «останнього резерву».

Оновлено дані щодо використання фаготерапії за програмою відкритого доступу
21 пацієнт у 7 лікарнях з тяжкими загрозливими для життя бактеріальними інфекціями, які не відповідали на лікування антибіотиками, отримували фагопрепарати проти Staphylococcus aureus або Pseudomonas aeruginosa в рамках програми відкритого доступу